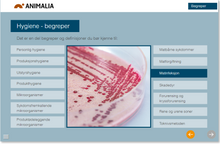
Load image into Gallery viewer, Kurs i hygieneopplæring for kjøttbransjen, eggbransjen og fjørfebransjen

Alle priser er eks. MVA.
Hvis du kjøper flere kurslisenser mottar du mail med registreringslenke og kode til ytterligere deltakere.
Hygiene er fundamentet for mattrygghet og forbrukerne må ha full tillit til kjøttbransjens produkter. Hygienekurset er tilpasset alle typer bedrifter innen kjøttindustrien, fra slakterier til foredlingsbedrifter.
Hva lærer du?
Hygienekurset er bygd opp rundt de krav som stilles fra myndighetene til kjøtt- og fjørfebedrifter. Kurset kan selvsagt ikke erstatte internkontroll og den løpende kvalitetssikringen av bedriftens hygieniske standard, men vil være et supplement til annen opplæring. Kurset består av følgende tema; personlig hygiene, produksjonshygiene, utstyrshygiene, smittestoffer, allergener og skadedyr, konservering og merking og kontroll og regelverk.
Etter gjennomført kurs får man en avsluttende test, som må bestås for å kunne skrive ut et kursbevis.
Kurset: «Hygiene – kjøtt» finnes også på engelsk, polsk og slovakisk.
Trenger du flere lisenser? Eller ønsker du å betale med faktura? - kontakt oss